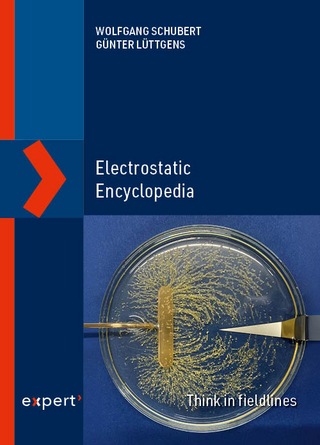
Electrostatic Encyclopedia

AI-powered cloud automation and optimization
Buch | Softcover
2025
|
Packt Publishing Limited
ISBN: 9781836200253
CHF 59,30 (inkl. MwSt)
- Versand in
15-20 Tagen